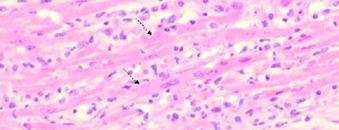

- Home
- Producten-en-diensten
- Pathologie
- Pathologie casussen
- Casussen rundvee
Pathologie casussen rundvee
Ziekte en sterfte hebben een grote impact op veehouderijen. Naast economische schade en een afname van het dierenwelzijn geeft het onzekerheid. Een snelle en effectieve strategie voor de aanpak is dan belangrijk. Pathologisch onderzoek op een gestorven dier geeft inzicht in de doodsoorzaak en levert mogelijk aanwijzingen op voor een bedrijfsprobleem. Deze essentiële informatie kan leiden tot een effectieve aanpak van de bestrijding van dierziekten. Vervolgens kunnen dierenarts en veehouder samen snel en effectief een behandeling inzetten en verdere economische schade beperken.

In deze casus beschrijven we een eerste geval van een BTV-3 geassocieerde aangeboren hersenafwijking bij een verworpen kalf.
Lees verder

Binnen 2 dagen 3 volwassen runderen gestorven onder verschijnselen van hoge koorts. Meerdere erg zieke runderen, waarvan de meesten in de loop van de volgende dagen ook gestorven zijn. IBR?
Lees verder
Plotseling dood. In één week zijn 15 kalveren doodgegaan waaronder 3 andere kalveren, die plotseling zijn overleden zonder voorafgaande symptomen.
Lees verder

Op basis van de klachten is er een vermoeden van een uitbraak van pinkengriep of IBR. De mucosa van de neusholte, larynx en trachea was bedekt met een beige, fibrinonecrotisch beslag.
Lees verder

Het kalf verkeerde in goede voedingstoestand. Na het openen van de schedel blijkt er sprake te zijn van een meningitis.
Lees verder